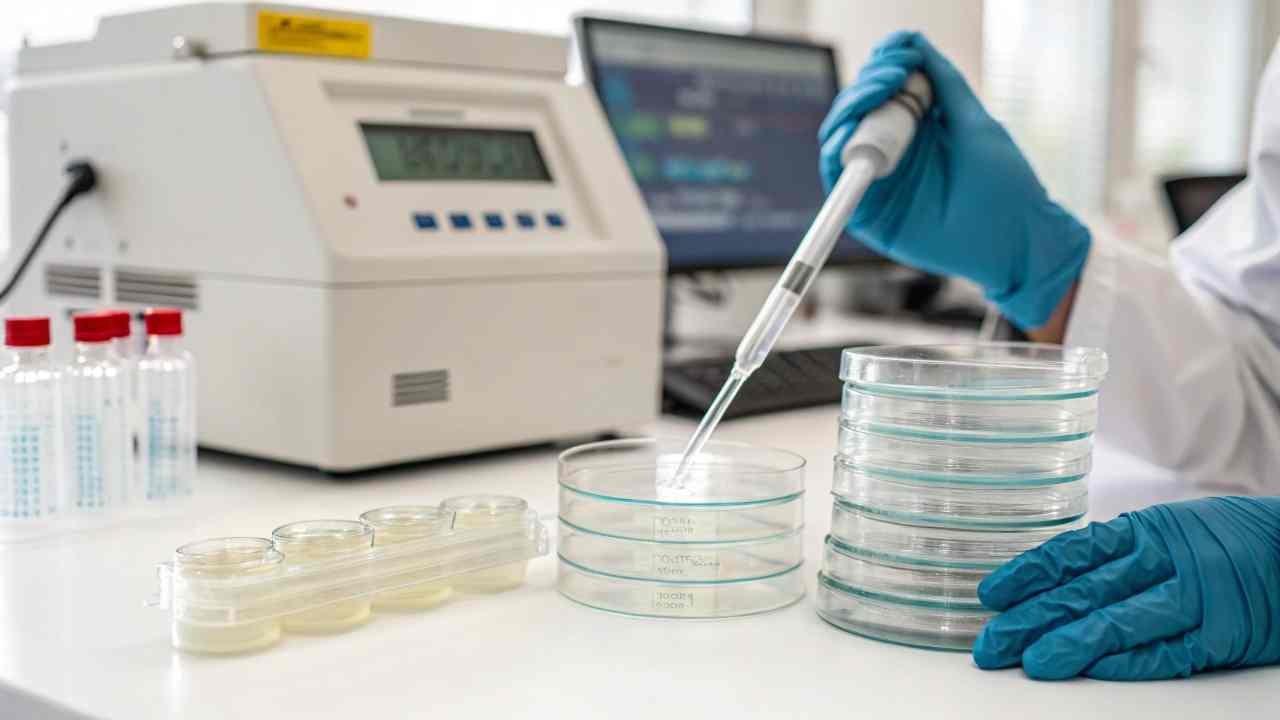

Low-quality Erythritol ruins your product taste and triggers expensive recalls. This risk destroys your brand reputation and drains capital. I provide technical oversight to ensure every shipment meets strict global standards.
Quality control for Erythritol ensures 99.5% purity through HPLC testing and strict microbial limits. It prevents contamination from heavy metals or unwanted fermentation by-products. Rigorous audits and correct documentation protect buyers from customs rejections and product failure in international food and beverage markets.

I manage factory selection and oversee production for my B2B clients in China. I want to share the technical facts about quality management so you can secure a safe supply chain for your wholesale business.
How is Erythritol tested for purity and safety?
Contaminated sweeteners cause health scares and legal trouble for your company. This danger stops your business growth. I identify the mandatory testing protocols that keep your Erythritol shipments safe and compliant.
Erythritol is tested using High-Performance Liquid Chromatography (HPLC) to verify the 99.5% minimum assay. Safety tests include heavy metal analysis for lead and arsenic, along with microbial plating to ensure the product is free from Salmonella, E. coli, yeast, and mold.
Technical Testing Standards and Protocols
I see that purity is the most important technical spec for my buyers. To confirm this, the factory lab must use HPLC1. This machine separates the molecules to show exactly how much Erythritol is in the sample. A standard result should be between 99.5% and 100.5%. If the result is lower, the product is off-spec. I also check the moisture levels using a drying oven. Erythritol must have less than 0.2% moisture. If it is too wet, the crystals will clump together in the drum. This makes it impossible for you to use in automated production lines. I visit the labs in Shandong to ensure their equipment is calibrated correctly.
Microbial safety2 is another critical area for food grade material. Erythritol is made through fermentation, so we must ensure no bad bacteria remain. I review the lab logs for Total Plate Count (TPC). The limit is usually less than 1000 cfu/g. I also demand negative results for pathogens. These include E. coli and Salmonella. If these are present, the whole batch must be destroyed. I also monitor the physical properties. I check the pH level of a 10% solution. It should be between 5.0 and 7.0. I also verify the melting point, which is around 121°C. These technical checks ensure the sweetener behaves correctly in your recipes. I act as your technical gatekeeper in China to confirm these facts.
Key Quality Testing Parameters
| Testing Parameter | Acceptable Limit | Technical Method | Importance |
|---|---|---|---|
| Assay (Purity) | 99.5% - 100.5% | HPLC | Ensures sweetness and value |
| Moisture | Max 0.20% | Loss on Drying | Prevents caking and clumping |
| Ash Content | Max 0.10% | Gravimetric | Indicates mineral purity |
| Arsenic (As) | Max 0.1 ppm | Atomic Absorption | Human safety / Compliance |
| Lead (Pb) | Max 0.1 ppm | Atomic Absorption | Global health standard |
| Total Plate Count | < 1000 cfu/g | Microbial Plating | Food safety and shelf life |
What impurities may exist in Erythritol?
Hidden impurities change the flavor profile of your final product. This inconsistency confuses your customers and hurts sales. I identify common impurities in Erythritol so you can avoid low-grade batches.
Impurities in Erythritol include residual reducing sugars, other polyols like ribitol or glycerol, and heavy metals. Furthermore, physical impurities like dust or black particles can occur if the factory filtration or cleanroom environment is not maintained to high GMP standards.

Fermentation By-products and Contaminants
I see that even high-purity Erythritol can have small amounts of "other polyols." These are created during the fermentation process. Yeast eats glucose but sometimes makes small amounts of ribitol or glycerol. If these levels are too high, the taste of the Erythritol changes. It might become less cool or have a strange aftertaste. I review the HPLC charts to look for these hidden peaks. I only accept batches where these by-products are at a minimum. I also check for "Reducing Sugars." These are leftover bits of glucose that the yeast did not eat. The limit is 0.3%. High sugar levels can cause browning when you bake with the Erythritol.
Heavy metals are a giant risk in the chemical industry. Arsenic and lead can come from the water or the raw corn starch used in the factory. I audit the water filtration systems at the plants. If they do not use high-quality ion exchange resins, the metal levels will be too high. I also watch for physical contaminants. This is a common problem in low-cost factories. If the air filters are old, you might find tiny black dots in the white crystals. This is usually carbon dust from the purification step. I perform a "Visual Inspection" of the open drums before they are sealed. This ensures the material is snow-white and clean. I act as your eyes on the factory floor to stop these impurities from reaching your warehouse.
Impurity Profile and Risk Level
| Impurity Type | Source | Impact | Risk Level |
|---|---|---|---|
| Reducing Sugars | Unfinished fermentation | Browning / Not sugar-free | Moderate |
| Ribitol / Glycerol | Yeast by-products | Altered taste profile | Low |
| Heavy Metals | Water / Raw materials | Toxic / Legal rejection | Very High |
| Black Particles | Carbon filter leak | Visual rejection | High |
| Excess Moisture | Poor drying | Caking and clumping | Moderate |
How do laboratory methods ensure Erythritol quality?
Inaccurate lab results lead to false security and future product failures. This technical error ruins your confidence in the supplier. I explain the professional lab methods that guarantee the quality of your Erythritol.
Laboratory methods ensure quality by using validated international standards like USP (US Pharmacopeia) or FCC (Food Chemicals Codex). Techniques such as Atomic Absorption Spectroscopy for metals and Refractive Index Detectors for purity provide objective data to confirm the product meets your specific requirements.

Precision Instrumentation and Methodology
I want you to understand that a "Certificate of Analysis" is only as good as the lab that made it. I only work with factories that have ISO 170253 certified labs. This means their methods are checked by third-party experts. For purity, we use HPLC with a Refractive Index (RI) detector. This is the technical standard for sugar alcohols. I check the "Retention Time" on the lab printouts. This proves the machine actually found Erythritol and not another substance. For heavy metals, we use Atomic Absorption (AA) or ICP-MS. These machines can find one part of lead in a million parts of Erythritol. This level of detail is required for exports to Europe and the USA.
I also focus on the "Sieving Test." This is a physical lab method. Erythritol comes in different mesh sizes, like 18-60 mesh or 100 mesh. The lab uses a stack of vibrating screens to measure the crystal size. If the crystals are too large, they will not dissolve in your soda. If they are too small, they will turn into a hard block during shipping. I oversee these sieving reports for my clients. I also check the "Ash Content" by burning a sample at high heat. What remains are the minerals. A high ash count means the product was not washed properly. By using these scientific methods, I remove all the guesswork from your procurement. This professional approach is why my buyers trust me with their large-volume orders.
Comparison of Lab Methods
| Target Trait | Lab Equipment | Technical Goal | Reliability |
|---|---|---|---|
| Chemical Purity | HPLC-RI | Identify Erythritol % | Very High |
| Heavy Metals | ICP-MS / AA | Detect lead / arsenic | Very High |
| Crystal Size | Sieve Shaker | Match mesh size spec | High |
| Moisture Content | Halogen Moisture Meter | Check dryness | High |
| Microbial Load | Incubator / Petri dish | Find yeast and mold | High |
| Solution Color | Spectrophotometer | Ensure water-white clarity | High |
What documents should accompany Erythritol shipments?
Missing documents cause your container to be stuck at the port for weeks. This delay costs you high demurrage fees and lost sales. I manage the full document set to ensure your Erythritol clears customs fast and easy.
Every Erythritol shipment must include a Batch-Specific Certificate of Analysis (COA), a Health Certificate, and a Material Safety Data Sheet (MSDS). Furthermore, HALAL and KOSHER certificates, along with a Non-GMO statement, are required for most global food industry buyers to prove product suitability.

Essential Paperwork for Customs and Compliance
I see that "Paperwork" is a technical requirement for smooth trade. The most important paper is the COA. It must show the batch number and the production date. I check that the results on the COA match the actual lab tests I oversaw. If the numbers are just copied from an old batch, I reject it. Another key document is the Health Certificate issued by the Chinese government (GACC). This proves the factory is clean and safe for food production. My buyers in the Middle East and Southeast Asia always need this for their local health authorities. I ensure the name on the certificate matches your company name exactly to avoid any questions.
I also provide the MSDS. This tells your warehouse staff how to handle the material safely. It also lists the "HS Code," which is 2905499000 for Erythritol. Having the right code saves you from tax problems. For my clients in Europe and Russia, I provide a Non-GMO statement. This proves the corn used was not genetically modified. I also manage the HALAL and KOSHER papers. These must be from recognized bodies like MUI or Orthodox Union. I check the expiry dates on these certificates every month. If a certificate expires, your shipment might be rejected. I act as your administrative office in China to ensure every paper is perfect. This professional management keeps your supply chain moving without any stops.
Shipping Document Checklist
| Document Name | Technical Purpose | FINETECH's Role |
|---|---|---|
| COA | Proves batch quality | Match test data to specs |
| MSDS | Safety and HS Code info | Verify HS Code for customs |
| Health Cert | Government safety proof | Apply for official GACC seal |
| HALAL / KOSHER | Religious compliance | Check validity and batch link |
| Packing List | Detail of drums / pallets | Confirm net and gross weight |
| Non-GMO Cert | Origin verification | Trace raw material source |
How to maintain consistent Erythritol batch quality?
Variations between batches cause you to change your recipes every month. This inconsistency lowers your final product quality. I help you select factories with stable production to ensure your Erythritol is identical every time you buy.
Maintain consistency by sourcing from factories that use automated Distributed Control Systems (DCS) and standardized yeast strains. I also implement "Pre-shipment Samples" and "Retention Samples" to compare the current batch with previous orders, ensuring the taste and physical properties never change.

Automation and Standard Operating Procedures
I want you to know that consistency comes from machines, not people. I prioritize factories that use full DCS automation4. This computer system controls the fermentation tanks 24/7. It ensures the temperature and oxygen levels are exactly the same for every batch. If a factory uses manual valves, the quality will vary based on who is working that day. This is a technical risk for your business. I visit the control rooms to see the automation in action. I also check their Standard Operating Procedures (SOPs). This is the rule book for the workers. Every step of washing and drying must be identical. This is the only way to get the same 30-60 mesh crystals every month.
I also use "Retention Samples." Every time I ship a container, I keep 500g of that batch in my office. When you order again, I compare the new batch with the old sample. I check the color, the taste, and the flow of the crystals. If the new batch is different, I stop the shipment. This physical comparison is a technical requirement for high-level trade. I also monitor the "Yeast Strain5" used by the factory. If they change their yeast to save money, the taste of the Erythritol might change. I negotiate with the factory to keep the same strain for your orders. This long-term relationship management is how I protect your production line. Consistency is my promise to my wholesale partners.
Batch Consistency Checkpoints
| Consistency Check | Technical Target | Why it matters |
|---|---|---|
| Visual Match | Snow-white color | Consumer perception |
| Taste Test | Clean, cooling effect | Final product flavor |
| Mesh Distribution | 95% within spec | Solubility in production |
| DCS Log Review | Stable temp / PH curves | Chemical purity stability |
| Sample Compare | Same as previous batch | Zero recipe changes |
| COA Comparison | Trace specs over 12 months | Long-term reliability |
Conclusion
Quality control for Erythritol requires strict HPLC testing, impurity monitoring, and perfect documentation. I manage these technical steps at FINETECH to ensure your procurement is safe, stable, and profitable for your business.
-
Agilent – A comprehensive resource explaining how High-Performance Liquid Chromatography (HPLC) is used to separate and quantify chemical components. ↩
-
FoodSafety.gov – Official U.S. government dashboard detailing common foodborne pathogens and safety management. ↩
-
ISO – Official page for the ISO/IEC 17025 standard, detailing the requirements for the competence of testing and calibration laboratories. ↩
-
Emerson – Technical insights into Distributed Control Systems (DCS) and how automation improves consistency in large-scale industrial manufacturing. ↩
-
Oxford Academic – A scientific paper detailing the role of specific yeast strains, like Yarrowia lipolytica, in the industrial production of Erythritol. ↩
